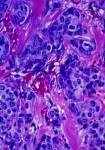

This Week’s Triple, Tough Dose of Real Stories on Women with Cancer
This news reminds us an aspect of cancer treatment some of us would rather put out of our heads….all cancer patients should take careful notes on their planned treatments and ask their doctors about the long-term consequences of therapy.